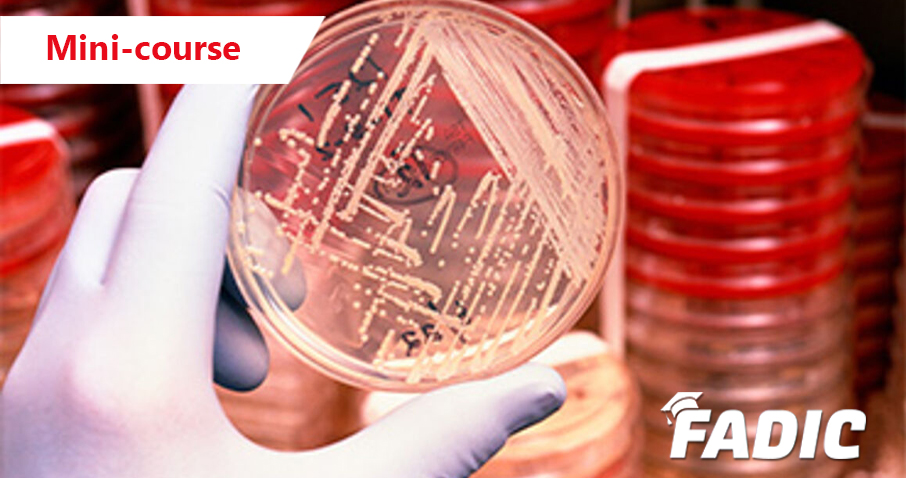
Antimicrobial Resistance Course

All
Schools/
Fellowship(5-6 Months) Certified Programs(2-4 Months) Mini Courses(3-4 Weeks) PrometricSPLE Course FADIC One-Day Workshops(1-2 Weeks) EnglishCourses Free Courses
Fellowship(5-6 Months) Certified Programs(2-4 Months) Mini Courses(3-4 Weeks) PrometricSPLE Course FADIC One-Day Workshops(1-2 Weeks) EnglishCourses Free Courses

 Log in
Log in Sign up
Sign up